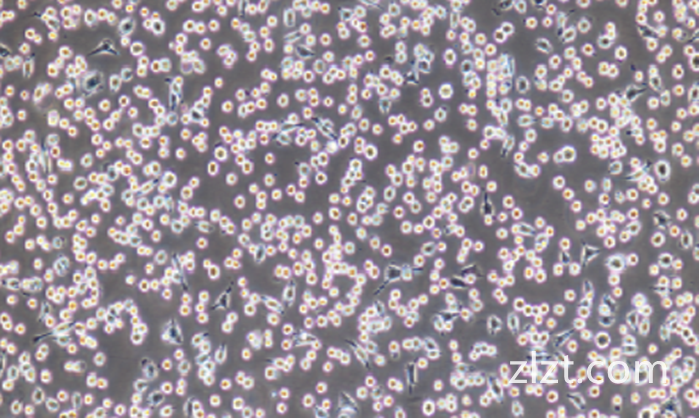
产品细节图片2

相关产品推荐更多 >
万千商家帮你免费找货
0 人在求购买到急需产品
- 详细信息
- 文献和实验
- 技术资料
- 细胞类型:
细胞系
- 供应商:
智立中特(武汉)生物科技有限公司
- 库存:
100
- 英文名:
TCCSUP
- 生长状态:
贴壁细胞
- 运输方式:
顺丰派送
- 器官来源:
人
- 细胞形态:
上皮细胞样
- 物种来源:
人
- 组织来源:
膀胱
- 规格:
1×10⁶cells/T25培养瓶
名称 TCCSUP(人膀胱癌细胞)(STR鉴定正确)
别称 TCCSuP;TCC-SUP;TCCSup
种属 人类
年龄(性别) 女性,67岁
组织来源 膀胱
生长特性 贴壁细胞
细胞形态 上皮细胞样
背景描述 TheTCCSUPlinewasisolatedin1974fromananaplastictransitionalcellcarcinoma(TCC)intheneckoftheurinarybladder.
生物安全等级 1
生长培养基 MEM+10%FBS+1%P/S
推荐传代比例 1:2-1:3
推荐换液频率 2~3次/周
倍增时间 ~28小时(PubMed=3708594);46小时(PubMed=25984343);49.2小时(PubMed=26055179);~30-40小时(DSMZ).
冻存条件
冻存液:55%基础培养基+40%FBS+5%DMSO
温度:液氮
培养条件
气相:空气,95%;CO2,5%
温度:37℃
抗原表达情况 HLA2,3,7,12
保藏机构 ATCC;HTB-5DSMZ;ACC-377

运输和保存
干冰运输及复苏好存活细胞
(1)1mL冻存管包装干冰运输,收到后-80度冰箱保存过夜后转入液氮或直接复苏,若发现干冰已挥发干净、冻存管瓶盖脱落、破损及细胞有污染,请立即与我们联系。
(2)T25瓶复苏的存活细胞常温发货,收到后按照细胞接收后的处理方法操作。
细胞接收后的处理
1)收到细胞后,75%酒精消毒瓶壁将T25瓶置于37℃培养箱放置约2-3h,若发现培养瓶破损、有液溢出及细胞有污染,请拍照后及时联系我们。
2)请在4或5X显微镜下确认细胞状态,同时给刚收到的细胞拍照(10×,20×)各2-3张以及培养瓶外观照片一张留存,作为售后时收到时细胞状态的依据。
3)贴壁细胞:细胞在37℃培养箱中放置2-3h,显微镜下观察细胞的生长和贴壁情况,有些贴壁细胞在快递运送过程中会因振动脱落和脱落后成团的情况。若镜下观察细胞的生长密度若在60%以下,可去除培养瓶中灌液培养基(若有未贴壁的细胞需要离心回收,重悬打入到原培养瓶中),加入新配制的完全培养基6-8mL,放到细胞培养箱中继续培养。若细胞生长密度达70%-80%以上,可以对细胞进行传代处理。传代过程中,若因运输振动脱落的细胞需要离心回收。
4)备注:运输用的培养基(灌液培养基)不能再用来培养细胞,请换用按照说明书细胞培养条件新配制的完全培养基来培养细胞。收到细胞后第一次传代建议T25培养瓶1:2传代。
一.培养基及培养冻存条件准备:
1)准备DMEM/F12培养基;优质胎牛血清,10%;400ng/mL氢化可的松,1mM丙 ,酮酸钠,双抗,1%。
2)培养条件:气相:空气,95%;二氧化碳,5%。温度:37摄氏度,培养箱湿度为70%-80%。
3)冻存液:90%血清,10%DMSO,现用现配。
二.细胞处理:
1)冻存细胞的复苏:
将含有1mL细胞悬液的冻存管在37℃水浴中迅速摇晃解冻,加入到含4-6mL完全培养基的离心管中混合均匀。在1000RPM条件下离心3-5min,弃去上清液,完全培养基重悬细胞。然后将细胞悬液加入含6-8ml完全培养基的培养瓶(或皿)中37℃培养过夜。第二天显微镜下观察细胞生长情况和细胞密度。
2)细胞传代:如果细胞密度达80%-90%,即可进行传代培养。
对于贴壁细胞传代可以参考以下方法
1.弃去培养上清,用不含钙、镁离子的PBS润洗细胞1-2次。
2.加入0.25%(w/v)胰蛋白酶-0.53mMEDTA于培养瓶中(T25瓶1-2mL,T75瓶2-3mL),置于37℃培养箱中消化1-2分钟(难消化的细胞可以适当延长消化时间),然后在显微镜下观察细胞消化情况,若细胞大部分变圆并脱落,迅速拿回操作台,轻敲几下培养瓶后加入3-4ml含10%FBS的培养基来终止消化。
3.轻轻打匀后吸出,在1000RPM条件下离心3-5min,弃去上清液,补加1-2mL培养液后吹匀。将细胞悬液按1:2的比例分到新T25瓶中,添加6-8ml按照说明书要求配置的新的完全培养基以保持细胞的生长活力,后续传代根据实际情况按1:2~1:5的比例进行。
3)细胞冻存:收到细胞后建议在培养前3代时冻存一批细胞种子以备后续实验使用。
下面T25瓶为例;
1.细胞冻存时按照细胞传代的过程收集消化好的细胞到离心管中,可使用血球计数板计数,来决定细胞的冻存密度。一般细胞的推荐冻存密度为1×106~1×107个活细胞/ml.
2.1000rpm离心3-5min,去掉上清。用配制好的细胞冻存液重悬细胞,按每1ml冻存液含1×106~1×107个活细胞/ml分配到一个冻存管中将细胞分配到冻存管中,标注好名称、代数、日期等信息。
3.将要冻存的细胞置于程序降温盒中,-80度冰箱中过夜,之后转入液氮容器中储存。同时记录好冻存管在液氮容器中的位置以便后续查阅和使用。


风险提示:丁香通仅作为第三方平台,为商家信息发布提供平台空间。用户咨询产品时请注意保护个人信息及财产安全,合理判断,谨慎选购商品,商家和用户对交易行为负责。对于医疗器械类产品,请先查证核实企业经营资质和医疗器械产品注册证情况。
 文献和实验
文献和实验癌细胞存在微卫星DNA不稳定性[21]。随后,在胰腺癌、低分化胃癌[22]、子宫内膜癌[23]、膀胱癌[24]、遗传性非息肉样结直肠癌[25]和卵巢癌的癌细胞中也发现了MI的存在。 [1]Edwards A,Civitello A,Hammond HA etal.DNA typing and genetic mapping with trimeric and tetrameric tandem repeats [J].Am J Hum Genet,1991,49(4):746-756
大麦克马斯特大学的一个研究小组在人类干细胞中发现了一个独特的细胞亚群,这些细胞似乎可以指示周围细胞如何发育和生长。研究人员将其命名为“Kingpin”细胞,这类细胞的发现,以及鉴定细胞的过程,将为科学家们开辟一条新的研究道路,帮助我们更好的了解癌细胞的生长,以及人类干细胞如何做出决定的作用机制。这一研究成果公布在4月12日的Cell杂志上。领导这一研究的麦克马斯特大学干细胞和癌症研究所主任Mick Bhatia说:“我们发现了一个不为人知的细胞群,它似乎是维持和培育所有其他细胞所需干细胞生态系统的‘带头
细胞示踪技术广泛应用于活细胞在体内环境下的生物学行动,尤其是在细胞移植研究领域,对于细胞移植后在体内的存活,分布,分化,迁移,转归等的观察提供研究基础。科佰生物提供可以稳定表达Luciferase,GFP,RFP的示踪细胞株:上千株现货示踪细胞株,包含全身各个组织器官,物种包含人和小鼠,支持定制,满足您的全方位需求;母细胞经过STR鉴定,部分细胞做过体内异位成瘤验证;全部稳定株细胞的信噪比大于1000倍,经过16代体外稳定性测试,完美满足体内示踪实验。示踪细胞株的应用十分广泛,尤其是在细胞
 技术资料
技术资料暂无技术资料 索取技术资料










